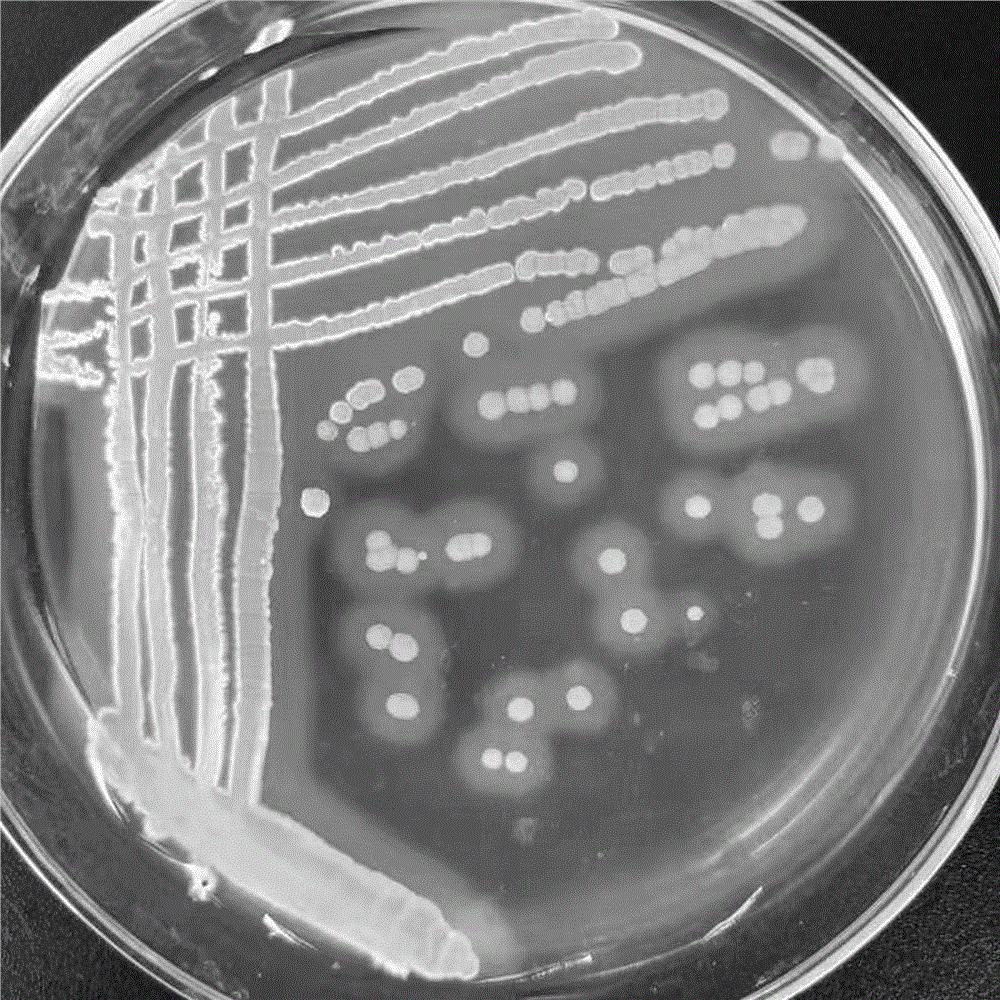
cn110468086a_一株灰色链霉菌hl-50及其复合菌剂与应用有效

灰色链霉菌

灰色链霉菌成美新泽西州"州微生物"
图片尺寸720x540
灰色链霉菌
图片尺寸640x480
一种链霉菌及其在防治甘蔗凤梨病中的应用
图片尺寸604x604
链霉菌
图片尺寸595x793
灰霉菌菌丝形态
图片尺寸736x450
一株灰色链霉菌hl-50及其复合菌剂与应用的制作方法
图片尺寸1000x1000
cn110468086a_一株灰色链霉菌hl-50及其复合菌剂与应用有效
图片尺寸1000x1000
延时显微镜有助于揭示链霉菌生命周期中的制动机制
图片尺寸400x343
一株阿洛杰链霉菌bc1及其应用
图片尺寸1046x1031
产色链霉菌
图片尺寸576x430
冰箱霉菌深灰色霉菌真菌生长照片
图片尺寸450x300
富产几丁质酶的链霉菌菌株筛选及其产酶条件优化
图片尺寸400x300
放线菌:主要分布在链霉菌属(streptomyces) 藻类:主要分布在小球藻属
图片尺寸1080x810
科学家解析链霉菌高产菌株高效绿色构建(1)
图片尺寸465x310
石垣链霉菌
图片尺寸268x268
链霉菌属
图片尺寸290x228
一种灰霉病菌实验室材料的常备形态及其制备与应用方法技术
图片尺寸995x1000
干酪乳杆菌
图片尺寸400x300
灰霉病复配的最佳配方灰霉病的病症
图片尺寸800x320
黑化链霉菌
图片尺寸300x300